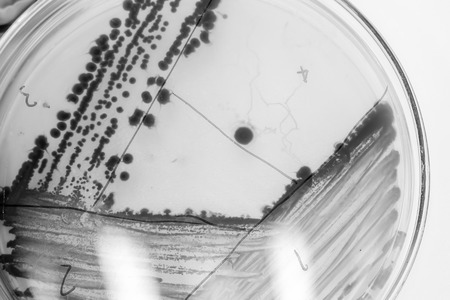
bacteria colony in petridish with black and white colourの写真素材

写真素材 - bacteria colony in petridish with black and white colour
作品情報
bacteria colony in petridish with black and white colour
- ID:83635458
- 作品種別:写真
- 作者名:thitiya mangprayool
キーワード
- agar
- antibiotic
- bacteria
- bacterial
- biology
- biotechnology
- blue
- chemical
- colony
- culture
- dish
- drug
- education
- experiment
- experimental
- fungi
- grow
- growth
- healthcare
- investigation
- lab
- laboratory
- macro
- medical
- medicine
- microbiology
- microorganisms
- molecular
- organism
- penicillin
- penicillum
- petri
- plate
- research
- science
- slant
- strain
- study
- test tube
- tube
類似作品
bacteria colony...
Petri dish with...
Petri dish show...
iron textures
A petri dish co...
Colony characte...
Shimmer bubbles...
Glitter blobs. ...
The mesmerizing...
Close-up of dar...
Backgrounds of ...
Backgrounds of ...
Backgrounds of ...
Backgrounds of ...
Backgrounds of ...
Bacterial cultu...
A vibrant ecosy...
Microbial Art
Petri Dish Art
Backgrounds of ...
Backgrounds of ...
Explore the uns...
Petri plate wit...
Close-up of a s...
Word biohazard ...
Microscopic bac...
Backgrounds of ...
Backgrounds of ...
In the microsco...
Bacterial colon...
microbial cultu...
petri dish with...
Close up of bac...
Gloved hand hol...
bacterial inocu...
Backgrounds of ...
The scientist i...
Close-up of bac...
Glowing colonie...
A vibrant displ...
bacteria colony...
A petri dish wi...
petri dish with...
grown up Asperg...
close-up of vib...
Colony characte...
microbial cultu...
photo of fungi ...
Top view of a p...